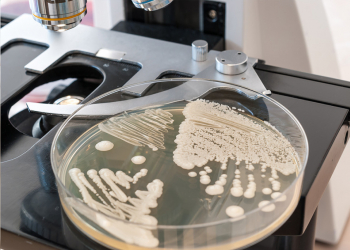
Candida: commensal organism and emerging multidrug-resistant pathogen

-
The new Directive (EU) 2020/2184, that has been recently adopted, aims at improving the quality of water for consumption. Learn all about the new crucial microbiological parameter for domestic water

Legionella spp.: new parameter in the control of water for consumption
Read more
Published: 24/03/21 12:47 | Categories: Microbiology -
The ocean temperature risings will increase the risk of foodborne infections and will allow the propagation to regions where there used to be a low incidence.

How does the climate crisis is already affecting food safety?
Read more
Published: 24/03/21 12:26 | Categories: Microbiology -
This first semester we return with the CondalabTalks, where we will touch essential topics in Pharma, Cosmetics and Food Safety. Join us, registrations for the first one are now open!

Upcoming CondalabTalks: January - June 2021
Read more
Published: 26/01/21 15:46 | Categories: Microbiology -
Resistance of microorganisms to antimicrobial substances is a topic of great concern to scientists around the world.
Candida: commensal organism and emerging multidrug-resistant pathogen
Read more
Published: 18/01/21 09:18 | Categories: Microbiology -
Food quality control is a method that is performed daily by thousands of laboratories, it is a simple procedure but it can cause problems with the results

Diluents. Essential or inconsequential in food analysis?
Read more
Published: 18/01/21 09:10 | Categories: Microbiology -
Salmonella is a well known pathogen due to the infections that it can cause through food. However, we can also get sick with this gram negative through pills and other non-sterile drugs.

Is it possible to get salmonellosis from medications?
Read more
Published: 18/01/21 08:55 | Categories: Microbiology -
Endotoxins are a major concern in cell cultures. As a solution for our clients, we have created Condalow, a new range of peptones. Check it out!

There are GMO and animal free, but is an endotoxin-free product possible?
Read more
Published: 26/11/20 09:26 | Categories: Microbiology -
Enterococcus: key indicator in water quality assurance
Read more
Published: 23/11/20 17:15 | Categories: Microbiology
Last blog news
News categories
Search on news

 Microbiology changes its color: The prevalence of chromogenic media
Microbiology changes its color: The prevalence of chromogenic media
 Probiotics: Which ones are good?
Probiotics: Which ones are good?
 Food fraud: How do we detect it?
Food fraud: How do we detect it?
 PCR: The Technique Revolutionizing Rapid Detection in the Food Industry
PCR: The Technique Revolutionizing Rapid Detection in the Food Industry
 Condalab Says YES to the World’s Leading Lab Trade Fair: Analytica 2026
Condalab Says YES to the World’s Leading Lab Trade Fair: Analytica 2026
